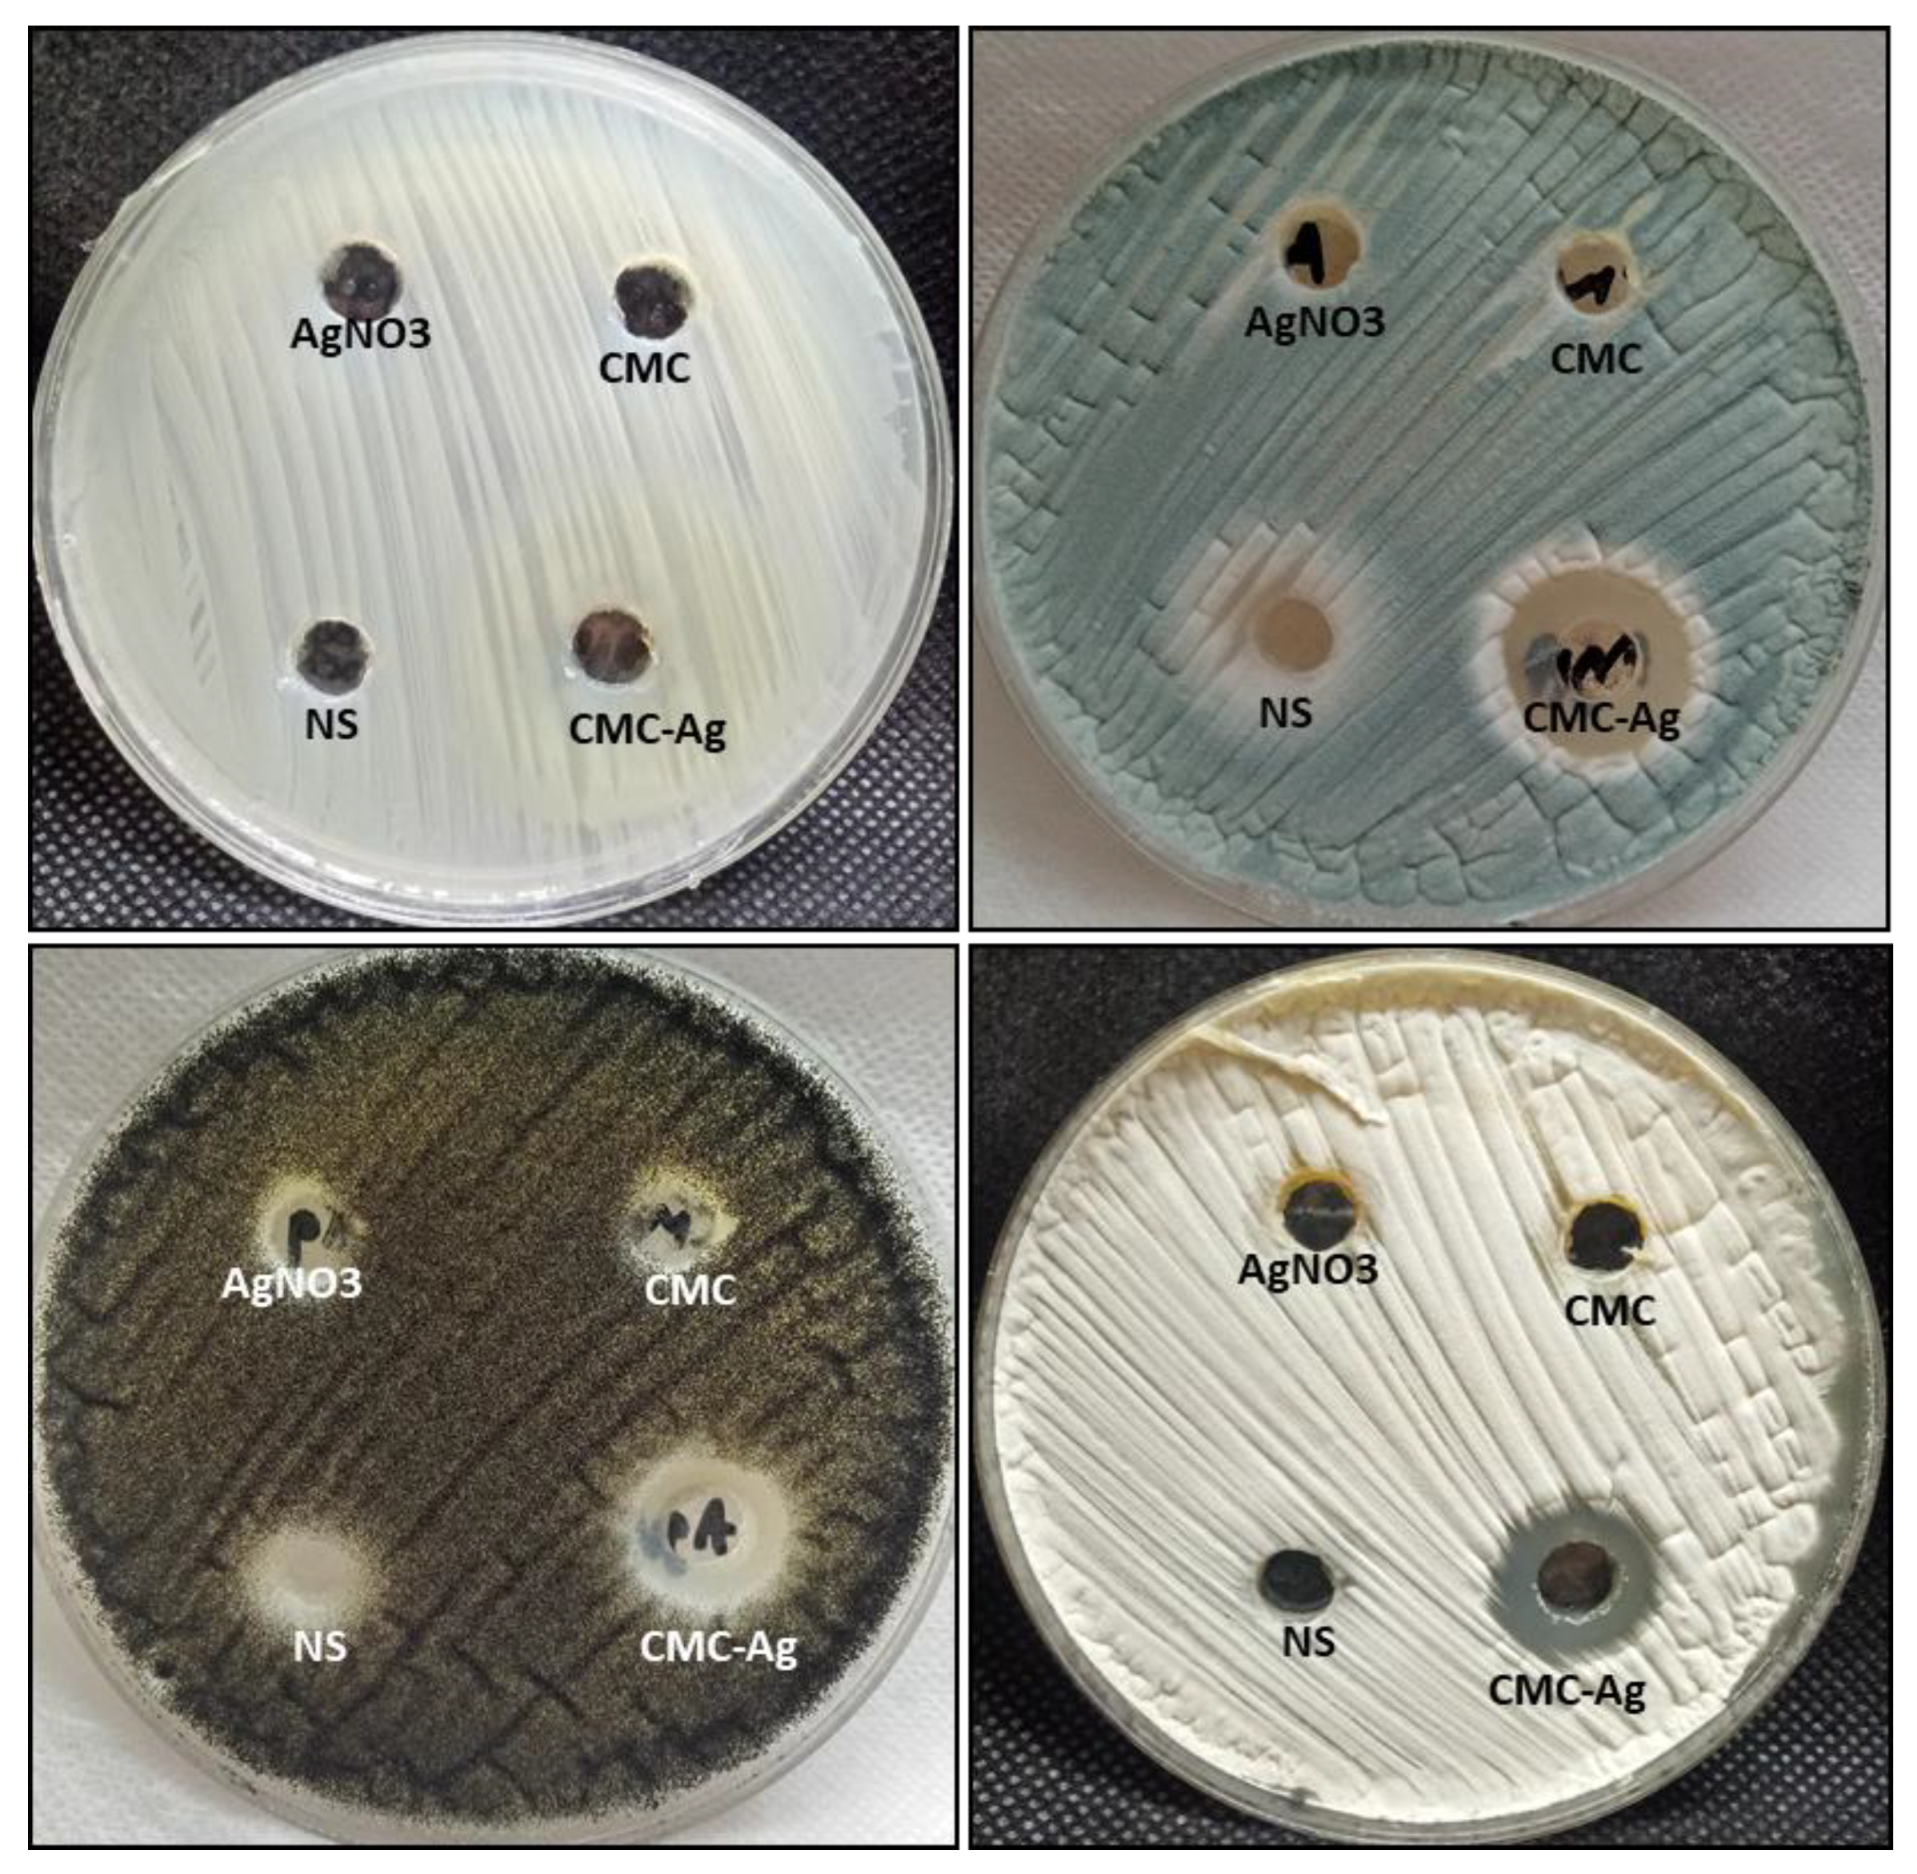
Polymers 14 03352 g003

Synthesis of Silver Nanocomposite Based on Carboxymethyl Cellulose: Antibacterial, Antifungal and Anticancer Activities
Abstract
:1. Introduction
2. Materials and Methods
2.1. Chemical and Reagents Used
2.2. Synthesis of Carboxymethyl Cellulose/Silver Nanoparticles (CMC-AgNPs)
2.3. Characterization of CMC-AgNPs
2.4. In Vitro Antibacterial Activity and MIC Determination
2.5. Antifungal Activity
2.6. Anticancer Activity
2.6.1. Cell Lines
2.6.2. Cell Viability Assay
2.7. Assessment of Caspase-8 and -9 Activities and VEGFR-2
2.8. Flow Cytometric Analysis
2.9. Statistical Analysis
3. Result and Discussion
3.1. Characterization of CMC-AgNPs
3.2. Antibacterial Activity and MIC Index
3.3. Antifungal Activity
3.4. Anticancer Activity
3.4.1. Cytotoxic Effect of CMC-AgNPs against HepG2 and MCF-7 Cell Lines
3.4.2. Effect of CMC-AgNPs on VEGFR-2
3.4.3. Effect of CMC-AgNPs on Caspase 8 and 9 Activities
3.4.4. Effect of CMC-AgNPs on Apoptosis of HepG2 Cell Line
3.5. Cell Cycle Analysis
4. Conclusions
Author Contributions
Funding
Institutional Review Board Statement
Informed Consent Statement
Data Availability Statement
Acknowledgments
Conflicts of Interest
References
- Hawash, M.; Jaradat, N.; Eid, A.M.; Abubaker, A.; Mufleh, O.; Al-Hroub, Q.; Sobuh, S. Synthesis of novel isoxazole–carboxamide derivatives as promising agents for melanoma and targeted nano-emulgel conjugate for improved cellular permeability. BMC Chem. 2022, 16, 47. [Google Scholar] [CrossRef] [PubMed]
- Hawash, M. Highlights on specific biological targets; cyclin-dependent kinases, epidermal growth factor receptors, ras protein, and cancer stem cells in anticancer drug development. Drug Res. 2019, 69, 471–478. [Google Scholar] [CrossRef] [PubMed]
- Doghish, A.S.; Ismail, A.; El-Mahdy, H.A.; Elkady, M.A.; Elrebehy, M.A.; Sallam, A.-A.M. A review of the biological role of miRNAs in prostate cancer suppression and progression. Int. J. Biol. Macromol. 2021, 197, 141–156. [Google Scholar] [CrossRef] [PubMed]
- Eid, A.M.; Hawash, M. Biological evaluation of Safrole oil and Safrole oil Nanoemulgel as antioxidant, antidiabetic, antibacterial, antifungal and anticancer. BMC Complement. Med. Ther. 2021, 21, 159. [Google Scholar] [CrossRef]
- Elkady, H.; Elwan, A.; El-Mahdy, H.A.; Doghish, A.S.; Ismail, A.; Taghour, M.S.; Elkaeed, E.B.; Eissa, I.H.; Dahab, M.A.; Mahdy, H.A. New benzoxazole derivatives as potential VEGFR-2 inhibitors and apoptosis inducers: Design, synthesis, anti-proliferative evaluation, flowcytometric analysis, and in silico studies. J. Enzym. Inhib. Med. Chem. 2022, 37, 403–416. [Google Scholar] [CrossRef]
- Terreni, M.; Taccani, M.; Pregnolato, M. New antibiotics for multidrug-resistant bacterial strains: Latest research developments and future perspectives. Molecules 2021, 26, 2671. [Google Scholar] [CrossRef]
- Chang, Y.-L.; Yu, S.-J.; Heitman, J.; Wellington, M.; Chen, Y.-L. New facets of antifungal therapy. Virulence 2017, 8, 222–236. [Google Scholar] [CrossRef]
- Campoy, S.; Adrio, J.L. Antifungals. Biochem. Pharmacol. 2017, 133, 86–96. [Google Scholar] [CrossRef]
- GAFFI, GP. How 150 People die Every Hour from Fungal Infection While the World Turns a Blind Eye. Global Action Fund for Fungal Infections (GAFFI). 2013. Available online: https://gaffi.org/global-plague-how-150-people-die-every-hour-from-fungal-infection-while-the-world-turns-a-blind-eye/ (accessed on 8 August 2022).
- Brown, G.D.; Denning, D.W.; Gow, N.A.; Levitz, S.M.; Netea, M.G.; White, T.C. Hidden killers: Human fungal infections. Sci. Transl. Med. 2012, 4, 165rv113. [Google Scholar] [CrossRef]
- Salem, S.S.; Hammad, E.N.; Mohamed, A.A.; El-Dougdoug, W. A Comprehensive Review of Nanomaterials: Types, Synthesis, Characterization, and Applications. Biointerface Res. Appl. Chem. 2022, 13, 41. [Google Scholar] [CrossRef]
- Badawy, A.A.; Abdelfattah, N.A.H.; Salem, S.S.; Awad, M.F.; Fouda, A. Efficacy Assessment of Biosynthesized Copper Oxide Nanoparticles (CuO-NPs) on Stored Grain Insects and Their Impacts on Morphological and Physiological Traits of Wheat (Triticum aestivum L.) Plant. Biology 2021, 10, 233. [Google Scholar] [CrossRef] [PubMed]
- Salem, S.S.; Ali, O.M.; Reyad, A.M.; Abd-Elsalam, K.A.; Hashem, A.H. Pseudomonas indica-Mediated Silver Nanoparticles: Antifungal and Antioxidant Biogenic Tool for Suppressing Mucormycosis Fungi. J. Fungi 2022, 8, 126. [Google Scholar] [CrossRef] [PubMed]
- Mohamed, A.A.; Abu-Elghait, M.; Ahmed, N.E.; Salem, S.S. Eco-friendly Mycogenic Synthesis of ZnO and CuO Nanoparticles for In Vitro Antibacterial, Antibiofilm, and Antifungal Applications. Biol. Trace Element Res. 2020, 199, 2788–2799. [Google Scholar] [CrossRef] [PubMed]
- Sharaf, M.H.; Nagiub, A.M.; Salem, S.S.; Kalaba, M.H.; El Fakharany, E.M.; El-Wahab, H.A. A new strategy to integrate silver nanowires with waterborne coating to improve their antimicrobial and antiviral properties. Pigment Resin Technol. 2022, in press. [Google Scholar] [CrossRef]
- Hasanin, M.; Hashem, A.H.; Lashin, I.; Hassan, S.A.M. In vitro improvement and rooting of banana plantlets using antifungal nanocomposite based on myco-synthesized copper oxide nanoparticles and starch. Biomass-Convers. Biorefinery 2021, 1–11. [Google Scholar] [CrossRef]
- Hashem, A.H.; Al Abboud, M.A.; Alawlaqi, M.M.; Abdelghany, T.M.; Hasanin, M. Synthesis of nanocapsules based on biosynthesized nickel nanoparticles and potato starch: Antimicrobial, antioxidant, and anticancer activity. Stärke 2022, 74, e2100165. [Google Scholar] [CrossRef]
- Elbasuney, S.; El-Sayyad, G.S.; Tantawy, H.; Hashem, A.H. Promising antimicrobial and antibiofilm activities of reduced graphene oxide-metal oxide (RGO-NiO, RGO-AgO, and RGO-ZnO) nanocomposites. RSC Adv. 2021, 11, 25961–25975. [Google Scholar] [CrossRef]
- Shams, R.; Rizvi, Q.E.H.; Dar, A.H.; Majid, I.; Khan, S.A.; Singh, A. Polysaccharides: Promising Constituent for the Preparation of Nanomaterials. In Polysaccharides: Properties and Applications; Scrivener Publishing: Beverly, MA, USA, 2021; pp. 441–457. [Google Scholar] [CrossRef]
- Salem, S.S.; Fouda, A. Green Synthesis of Metallic Nanoparticles and Their Prospective Biotechnological Applications: An Overview. Biol. Trace Elem. Res. 2020, 199, 344–370. [Google Scholar] [CrossRef]
- Shehabeldine, A.M.; Salem, S.S.; Ali, O.M.; Abd-Elsalam, K.A.; Elkady, F.M.; Hashem, A.H. Multifunctional Silver Nanoparticles Based on Chitosan: Antibacterial, Antibiofilm, Antifungal, Antioxidant, and Wound-Healing Activities. J. Fungi 2022, 8, 612. [Google Scholar] [CrossRef]
- Hashem, A.H.; Shehabeldine, A.M.; Ali, O.M.; Salem, S.S. Synthesis of Chitosan-Based Gold Nanoparticles: Antimicrobial and Wound-Healing Activities. Polymers 2022, 14, 2293. [Google Scholar] [CrossRef]
- Abu-Elghait, M.; Hasanin, M.; Hashem, A.H.; Salem, S.S. Ecofriendly novel synthesis of tertiary composite based on cellulose and myco-synthesized selenium nanoparticles: Characterization, antibiofilm and biocompatibility. Int. J. Biol. Macromol. 2021, 175, 294–303. [Google Scholar] [CrossRef]
- Aref, M.S.; Salem, S.S. Bio-callus synthesis of silver nanoparticles, characterization, and antibacterial activities via Cinnamomum camphora callus culture. Biocatal. Agric. Biotechnol. 2020, 27, 101689. [Google Scholar] [CrossRef]
- Basuny, M.; Ali, I.O.; El-Gawad, A.A.; Bakr, M.F.; Salama, T.M. A fast green synthesis of Ag nanoparticles in carboxymethyl cellulose (CMC) through UV irradiation technique for antibacterial applications. J. Sol-Gel Sci. Technol. 2015, 75, 530–540. [Google Scholar] [CrossRef]
- Devi, B.L.; Rao, K.M.; Ramananda, D. Spectroscopic investigation of green synthesized ZnS nanoparticles encapsulated by sodium carboxy methyl cellulose. Appl. Phys. A 2020, 126, 1–11. [Google Scholar] [CrossRef]
- Prema, P.; Thangapandiyan, S.; Immanuel, G. CMC stabilized nano silver synthesis, characterization and its antibacterial and synergistic effect with broad spectrum antibiotics. Carbohydr. Polym. 2017, 158, 141–148. [Google Scholar] [CrossRef] [PubMed]
- El-Sheikh, M.; El-Rafie, S.; Abdel-Halim, E.; El-Rafie, M. Green synthesis of hydroxyethyl cellulose-stabilized silver nanoparticles. J. Polym. 2013, 2013, 650837. [Google Scholar] [CrossRef]
- Al-Rajhi, A.M.; Salem, S.S.; Alharbi, A.A.; Abdelghany, T. Ecofriendly synthesis of silver nanoparticles using Kei-apple (Dovyalis caffra) fruit and their efficacy against cancer cells and clinical pathogenic microorganisms. Arab. J. Chem. 2022, 15, 103927. [Google Scholar] [CrossRef]
- Nakpathom, M.; Somboon, B.; Narumol, N.; Mongkholrattanasit, R. High temperature dyeing of PET fabric with natural colourants extracted from annatto seeds. Pigment. Resin Technol. 2018, 48, 129–136. [Google Scholar] [CrossRef]
- Franci, G.; Falanga, A.; Galdiero, S.; Palomba, L.; Rai, M.; Morelli, G.; Galdiero, M. Silver nanoparticles as potential antibacterial agents. Molecules 2015, 20, 8856–8874. [Google Scholar] [CrossRef]
- Salem, S.S.; El-Belely, E.F.; Niedbała, G.; Alnoman, M.M.; Hassan, S.E.-D.; Eid, A.M.; Shaheen, T.I.; Elkelish, A.; Fouda, A. Bactericidal and In-Vitro Cytotoxic Efficacy of Silver Nanoparticles (Ag-NPs) Fabricated by Endophytic Actinomycetes and Their Use as Coating for the Textile Fabrics. Nanomaterials 2020, 10, 2082. [Google Scholar] [CrossRef]
- Jena, P.; Mohanty, S.; Mallick, R.; Jacob, B.; Sonawane, A. Toxicity and antibacterial assessment of chitosancoated silver nanoparticles on human pathogens and macrophage cells. Int. J. Nanomed. 2012, 7, 1805. [Google Scholar]
- Huy, T.Q.; Huyen, P.; Le, A.-T.; Tonezzer, M. Recent advances of silver nanoparticles in cancer diagnosis and treatment. Anti-Cancer Agents Med. Chem. 2020, 20, 1276–1287. [Google Scholar] [CrossRef] [PubMed]
- Păduraru, D.N.; Ion, D.; Niculescu, A.-G.; Mușat, F.; Andronic, O.; Grumezescu, A.M.; Bolocan, A. Recent Developments in Metallic Nanomaterials for Cancer Therapy, Diagnosing and Imaging Applications. Pharmaceutics 2022, 14, 435. [Google Scholar] [CrossRef] [PubMed]
- Capanema, N.S.; Carvalho, I.C.; Mansur, A.A.; Carvalho, S.M.; Lage, A.P.; Mansur, H.S. Hybrid hydrogel composed of carboxymethylcellulose–silver nanoparticles–doxorubicin for anticancer and antibacterial therapies against melanoma skin cancer cells. ACS Appl. Nano Mater. 2019, 2, 7393–7408. [Google Scholar] [CrossRef]
- Hussein, H.A.; Abdullah, M.A. Novel drug delivery systems based on silver nanoparticles, hyaluronic acid, lipid nanoparticles and liposomes for cancer treatment. Appl. Nanosci. 2021, 1–26. [Google Scholar] [CrossRef]
- Hebeish, A.; El-Rafie, M.; Abdel-Mohdy, F.; Abdel-Halim, E.; Emam, H. Carboxymethyl cellulose for green synthesis and stabilization of silver nanoparticles. Carbohydr. Polym. 2010, 82, 933–941. [Google Scholar] [CrossRef]
- Naseef, H.; Al-Maharik, N.; Rabba, A.K.; Sharifi-Rad, M.; Hawash, M.; Jaradat, N. Phytochemical characterization and assessments of antimicrobial, cytotoxic and anti-inflammatory properties of Lavandula coronopifolia Poir. volatile oil from Palestine. Arab. J. Chem. 2022, 15, 104069. [Google Scholar] [CrossRef]
- Balouiri, M.; Sadiki, M.; Ibnsouda, S.K. Methods for in vitro evaluating antimicrobial activity: A review. J. Pharm. Anal. 2016, 6, 71–79. [Google Scholar] [CrossRef]
- Diko, A. Laboratory Practical Work on Colony Count, Motility Test and Antimicrobial Susceptibility Test. J. Vet. Med. Health 2021, 5, 129. [Google Scholar]
- Okba, M.M.; Baki, P.M.A.; Abu-Elghait, M.; Shehabeldine, A.M.; El-Sherei, M.M.; Khaleel, A.E.; Salem, M.A. UPLC-ESI-MS/MS profiling of the underground parts of common Iris species in relation to their anti-virulence activities against Staphylococcus aureus. J. Ethnopharmacol. 2022, 282, 114658. [Google Scholar] [CrossRef]
- Elshikh, M.; Ahmed, S.; Funston, S.; Dunlop, P.; McGaw, M.; Marchant, R.; Banat, I.M. Resazurin-based 96-well plate microdilution method for the determination of minimum inhibitory concentration of biosurfactants. Biotechnol. Lett. 2016, 38, 1015–1019. [Google Scholar] [CrossRef]
- Siritongsuk, P.; Hongsing, N.; Thammawithan, S.; Daduang, S.; Klaynongsruang, S.; Tuanyok, A.; Patramanon, R. Two-phase bactericidal mechanism of silver nanoparticles against Burkholderia pseudomallei. PLoS ONE 2016, 11, e0168098. [Google Scholar] [CrossRef]
- Ali, O.M.; Hasanin, M.S.; Suleiman, W.B.; Helal, E.E.-H.; Hashem, A.H. Green biosynthesis of titanium dioxide quantum dots using watermelon peel waste: Antimicrobial, antioxidant, and anticancer activities. Biomass-Convers. Biorefinery 2022, 1–12. [Google Scholar] [CrossRef]
- Dacrory, S.; Hashem, A.H.; Hasanin, M. Synthesis of cellulose based amino acid functionalized nano-biocomplex: Characterization, antifungal activity, molecular docking and hemocompatibility. Environ. Nanotechnol. Monit. Manag. 2021, 15, 100453. [Google Scholar] [CrossRef]
- Dacrory, S.; Hashem, A.H.; Kamel, S. Antimicrobial and antiviral activities with molecular docking study of chitosan/carrageenan@ clove oil beads. Biotechnol. J. 2022, 17, 2100298. [Google Scholar] [CrossRef]
- Elbahnasawy, M.A.; Shehabeldine, A.M.; Khattab, A.M.; Amin, B.H.; Hashem, A.H. Green biosynthesis of silver nanoparticles using novel endophytic Rothia endophytica: Characterization and anticandidal activity. J. Drug Deliv. Sci. Technol. 2021, 62, 102401. [Google Scholar] [CrossRef]
- Wayne, P. CLSI document M27-A2; Reference Method for Broth Dilution Antifungal Susceptibility Testing of Yeasts. Approved Standard. 2002. Available online: https://cir.nii.ac.jp/crid/1570854176048718848 (accessed on 25 July 2022).
- Sanguinetti, M.; Posteraro, B.; Lass-Flörl, C. Antifungal drug resistance among Candida species: Mechanisms and clinical impact. Mycoses 2015, 58, 2–13. [Google Scholar] [CrossRef]
- Rojas, F.D.; Sosa, M.D.L.A.; Fernández, M.S.; Cattana, M.E.; Córdoba, S.B.; Giusiano, G. Antifungal susceptibility of Malassezia furfur, Malassezia sympodialis, and Malassezia globosa to azole drugs and amphotericin B evaluated using a broth microdilution method. Med Mycol. 2014, 52, 641–646. [Google Scholar] [CrossRef]
- Ciapetti, G.; Cenni, E.; Pratelli, L.; Pizzoferrato, A. In vitro evaluation of cell/biomaterial interaction by MTT assay. Biomaterials 1993, 14, 359–364. [Google Scholar] [CrossRef]
- Doghish, A.S.; El-Sayyad, G.S.; Sallam, A.-A.M.; Khalil, W.F.; El Rouby, W.M. Graphene oxide and its nanocomposites with EDTA or chitosan induce apoptosis in MCF-7 human breast cancer. RSC Adv. 2021, 11, 29052–29064. [Google Scholar] [CrossRef]
- Hawash, M.; Qneibi, M.; Jaradat, N.; Abualhasan, M.; Amer, J.; Amer, E.-H.; Ibraheem, T.; Hindieh, S.; Tarazi, S.; Sobuh, S. The impact of filtered water-pipe smoke on healthy versus cancer cells and their neurodegenerative role on AMPA receptor. Drug Chem. Toxicol. 2021, 1–9. [Google Scholar] [CrossRef]
- Elkady, M.A.; Doghish, A.S.; Elshafei, A.; Elshafey, M.M. MicroRNA-567 inhibits cell proliferation and induces cell apoptosis in A549 NSCLC cells by regulating cyclin-dependent kinase 8. Saudi J. Biol. Sci. 2021, 28, 2581–2590. [Google Scholar] [CrossRef]
- Farouk, M.M.; El-Molla, A.; Salib, F.A.; Soliman, Y.A.; Shaalan, M. The role of silver nanoparticles in a treatment approach for multidrug-resistant Salmonella species isolates. Int. J. Nanomed. 2020, 15, 6993. [Google Scholar] [CrossRef]
- Keasey, S.L.; Suh, M.-J.; Das, S.; Blancett, C.D.; Zeng, X.; Andresson, T.; Sun, M.G.; Ulrich, R.G. Decreased Antibiotic Susceptibility Driven by Global Remodeling of the Klebsiella pneumoniae Proteome. Mol. Cell. Proteom. 2019, 18, 657–668. [Google Scholar] [CrossRef]
- Yang, J.; Zhang, X.; Chen, L.; Zhou, X.; Fan, X.; Hu, Y.; Niu, X.; Xu, X.; Zhou, G.; Ullah, N. Antibacterial aerogels with nano-silver reduced in situ by carboxymethyl cellulose for fresh meat preservation. Int. J. Biol. Macromol. 2022, 213, 621–630. [Google Scholar] [CrossRef] [PubMed]
- Deng, H.; McShan, D.; Zhang, Y.; Sinha, S.S.; Arslan, Z.; Ray, P.C.; Yu, H. Mechanistic study of the synergistic antibacterial activity of combined silver nanoparticles and common antibiotics. Environ. Sci. Technol. 2016, 50, 8840–8848. [Google Scholar] [CrossRef]
- Rangarajan, S.; Verekar, S.; Deshmukh, S.K.; Bellare, J.R.; Balakrishnan, A.; Sharma, S.; Vidya, R.; Chimote, G. Evaluation of anti-bacterial activity of silver nanoparticles synthesised by coprophilous fungus PM0651419. IET Nanobiotechnol. 2018, 12, 106–115. [Google Scholar] [CrossRef]
- Shrifian-Esfahni, A.; Salehi, M.T.; Nasr-Esfahni, M.; Ekramian, E. Chitosan-modified superparamgnetic iron oxide nanoparticles: Design, fabrication, characterization and antibacterial activity. Chemik 2015, 69, 19–32. [Google Scholar]
- Martínez-Rodríguez, M.d.l.Á.; Madla-Cruz, E.; Urrutia-Baca, V.H.; de la Garza-Ramos, M.A.; González-González, V.A.; Garza-Navarro, M.A. Influence of polysaccharides’ molecular structure on the antibacterial activity and cytotoxicity of green synthesized composites based on silver nanoparticles and carboxymethyl-cellulose. Nanomaterials 2020, 10, 1164. [Google Scholar] [CrossRef]
- Chernousova, S.; Epple, M. Silver as antibacterial agent: Ion, nanoparticle, and metal. Angew. Chem. Int. Ed. 2013, 52, 1636–1653. [Google Scholar] [CrossRef]
- Saratale, R.G.; Shin, H.S.; Kumar, G.; Benelli, G.; Kim, D.-S.; Saratale, G.D. Exploiting antidiabetic activity of silver nanoparticles synthesized using Punica granatum leaves and anticancer potential against human liver cancer cells (HepG2). Artif. Cells Nanomed. Biotechnol. 2018, 46, 211–222. [Google Scholar] [CrossRef]
- Kassab, A.E.; Gedawy, E.M.; Hamed, M.I.A.; Doghish, A.S.; Hassan, R.A. Design, synthesis, anticancer evaluation, and molecular modelling studies of novel tolmetin derivatives as potential VEGFR-2 inhibitors and apoptosis inducers. J. Enzym. Inhib. Med. Chem. 2021, 36, 922–939. [Google Scholar] [CrossRef] [PubMed]
- Kumari, S.; Kumari, P.; Panda, P.K.; Patel, P.; Jha, E.; Mallick, M.A.; Verma, S.K. Biocompatible biogenic silver nanoparticles interact with caspases on an atomic level to elicit apoptosis. Nanomedicine 2020, 15, 2119–2132. [Google Scholar]
- Yuan, Y.-G.; Peng, Q.-L.; Gurunathan, S. Silver nanoparticles enhance the apoptotic potential of gemcitabine in human ovarian cancer cells: Combination therapy for effective cancer treatment. Int. J. Nanomed. 2017, 12, 6487. [Google Scholar] [CrossRef]
- Ciftci, H.; Türk, M.; Tamer, U.; Karahan, S.; Menemen, Y. Silver nanoparticles: Cytotoxic, apoptotic, and necrotic effects on MCF-7 cells. Turk. J. Biol. 2013, 37, 573–581. [Google Scholar] [CrossRef]
- Abd Elkodous, M.; El-Husseiny, H.M.; El-Sayyad, G.S.; Hashem, A.H.; Doghish, A.S.; Elfadil, D.; Radwan, Y.; El-Zeiny, H.M.; Bedair, H.; Ikhdair, O.A. Recent advances in waste-recycled nanomaterials for biomedical applications: Waste-to-wealth. Nanotechnol. Rev. 2021, 10, 1662–1739. [Google Scholar] [CrossRef]
- Bin-Jumah, M.; Monera, A.-A.; Albasher, G.; Alarifi, S. Effects of green silver nanoparticles on apoptosis and oxidative stress in normal and cancerous human hepatic cells in vitro. Int. J. Nanomed. 2020, 15, 1537. [Google Scholar] [CrossRef]
- Bastos, V.; Ferreira-de-Oliveira, J.M.; Carrola, J.; Daniel-da-Silva, A.L.; Duarte, I.F.; Santos, C.; Oliveira, H. Coating independent cytotoxicity of citrate-and PEG-coated silver nanoparticles on a human hepatoma cell line. J. Environ. Sci. 2017, 51, 191–201. [Google Scholar] [CrossRef] [PubMed]
- Panzarini, E.; Mariano, S.; Vergallo, C.; Carata, E.; Fimia, G.M.; Mura, F.; Rossi, M.; Vergaro, V.; Ciccarella, G.; Corazzari, M. Glucose capped silver nanoparticles induce cell cycle arrest in HeLa cells. Toxicol. In Vitro 2017, 41, 64–74. [Google Scholar] [CrossRef]

| Bacterial Strains | Growth-Inhibition Zone in mm (Mean ± SD) as Caused by Different Concentrations of CMC-AgNPs and AgNPs | ||||
|---|---|---|---|---|---|
| CMC-AgNPs 100 µg/mL | CMC-AgNPs 50 µg/mL | AgNPs 100 µg/mL | AgNPs 50 µg/mL | Ciprofloxacine | |
| Klebsiella oxytoca ATCC 51983 | 18.0 ± 0.91 | 12.0 ± 0.34 | 13.0 ± 0.81 | 8.2 ± 0.51 | 13.0 ± 2.3 |
| Escherichia coli ATCC 35218 | 17.0 ± 0.63 | 12.0 ± 0.27 | 14.0 ± 0.39 | 9.6 ± 0.51 | 15.0 ± 1.8 |
| Staphylococcus aureus ATCC 25923 | 12.0 ± 0.41 | 8.5 ± 0.3 | 9.5 ± 0.37 | 7.5 ± 0.27 | 14 ± 3.2 |
| Bacillus cereus ATTC 11778 | 11.0 ± 0.97 | 8.3 ± 0.6 | 8.5 ± 0.16 | 6.5 ± 0.37 | 16 ± 1.9 |
| Standard Bacterial Strains | MIC (μg/mL) | MBC (μg/mL) | MBC/MIC Ratio |
|---|---|---|---|
| Klebsiella oxytoca ATCC 51983 | 12.5 | 25.0 | 2 |
| Escherichia coli ATCC 35218 | 12.5 | 25.0 | 2 |
| Staphylococcus aureus ATCC 25923 | 25.0 | 100.0 | 4 |
| Bacillus cereus ATTC 11778 | 50.0 | 150.0 | 3 |
| C. albicans | A. fumigatus | A. niger | A. terreus | |||||
|---|---|---|---|---|---|---|---|---|
| IZ/mm (0.5 mg/mL) | MIC mg/mL | IZ/mm (0.5 mg/mL) | MIC mg/mL | IZ/mm (0.5 mg/mL) | MIC mg/mL | IZ/mm (0.5 mg/mL) | MIC mg/mL | |
| CMC | ND | ND | ND | ND | 9 | 0.5 | ND | ND |
| AgNO3 | ND | ND | ND | ND | 8 | 0.5 | ND | ND |
| CMC-AgNPs | ND | ND | 19 | 0.0312 | 15 | 0.125 | 16 | 0.125 |
| NS | ND | ND | 11 | 0.5 | 12 | 0.25 | ND | ND |
Publisher’s Note: MDPI stays neutral with regard to jurisdictional claims in published maps and institutional affiliations. |
© 2022 by the authors. Licensee MDPI, Basel, Switzerland. This article is an open access article distributed under the terms and conditions of the Creative Commons Attribution (CC BY) license (https://creativecommons.org/licenses/by/4.0/).
Share and Cite
Salem, S.S.; Hashem, A.H.; Sallam, A.-A.M.; Doghish, A.S.; Al-Askar, A.A.; Arishi, A.A.; Shehabeldine, A.M. Synthesis of Silver Nanocomposite Based on Carboxymethyl Cellulose: Antibacterial, Antifungal and Anticancer Activities. Polymers 2022, 14, 3352. https://doi.org/10.3390/polym14163352
Salem SS, Hashem AH, Sallam A-AM, Doghish AS, Al-Askar AA, Arishi AA, Shehabeldine AM. Synthesis of Silver Nanocomposite Based on Carboxymethyl Cellulose: Antibacterial, Antifungal and Anticancer Activities. Polymers. 2022; 14(16):3352. https://doi.org/10.3390/polym14163352
Chicago/Turabian StyleSalem, Salem S., Amr H. Hashem, Al-Aliaa M. Sallam, Ahmed S. Doghish, Abdulaziz A. Al-Askar, Amr A. Arishi, and Amr M. Shehabeldine. 2022. "Synthesis of Silver Nanocomposite Based on Carboxymethyl Cellulose: Antibacterial, Antifungal and Anticancer Activities" Polymers 14, no. 16: 3352. https://doi.org/10.3390/polym14163352
APA StyleSalem, S. S., Hashem, A. H., Sallam, A.-A. M., Doghish, A. S., Al-Askar, A. A., Arishi, A. A., & Shehabeldine, A. M. (2022). Synthesis of Silver Nanocomposite Based on Carboxymethyl Cellulose: Antibacterial, Antifungal and Anticancer Activities. Polymers, 14(16), 3352. https://doi.org/10.3390/polym14163352

